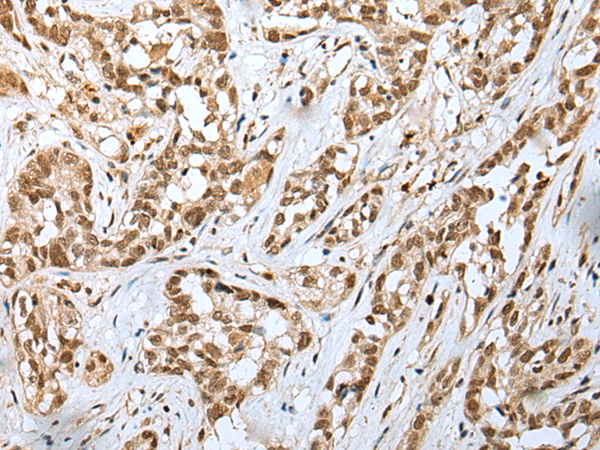
一抗

|
Background: |
The yeast heterotetrameric GINS complex is made up of Sld5, Psf1 (GINS1; MIM 610608), Psf2 (GINS2; MIM 610609), and Psf3 (GINS3; MIM 610610). The formation of the GINS complex is essential for the initiation of DNA replication in yeast and Xenopus egg extracts (Ueno et al., 2005 [PubMed 16287864]). See GINS1 for additional information about the GINS complex. |
|
Applications: |
ELISA, IHC |
|
Name of antibody: |
GINS4 |
|
Immunogen: |
Full length fusion protein |
|
Full name: |
GINS complex subunit 4 (Sld5 homolog) |
|
Synonyms: |
SLD5 |
|
SwissProt: |
Q9BRT9 |
|
ELISA Recommended dilution: |
5000-10000 |
|
IHC positive control: |
Human ovarian cancer |
|
IHC Recommend dilution: |
25-100 |

 購物車
購物車 幫助
幫助
 021-54845833/15800441009
021-54845833/15800441009